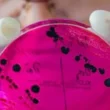

نظرة على إحصائيات عالمية حول النقرس
يعتبر النقرس من الأمراض المنتشرة عالمياً، حيث تشير التقديرات إلى أن نسبة الإصابة به على مستوى العالم تبلغ حوالي 0.3%. وتتفاوت هذه النسبة بشكل ملحوظ بين الدول المختلفة، ويعزى هذا التباين إلى عوامل متعددة تشمل البيئة، والتغذية، والوراثة. ففي الولايات المتحدة الأمريكية، تتراوح نسبة الإصابة بين الرجال من 5 إلى 13 حالة لكل 1000 شخص، بينما تتراوح بين النساء من 1 إلى 6 حالات لكل 1000 شخص، مع متوسط انتشار يبلغ حوالي 0.27% بين السكان بشكل عام. ومن الملاحظ أن الأشخاص الذين لديهم تاريخ عائلي للمرض تزيد لديهم نسبة الإصابة لتصل إلى 20%.
أما في المملكة المتحدة، فقد أظهرت الإحصائيات وجود 16 حالة لكل 1000 رجل و 3 حالات لكل 1000 امرأة. وتجدر الإشارة إلى أن شعب الماوري في نيوزيلندا يعاني من ارتفاع ملحوظ في نسبة الإصابة، حيث تصل إلى 10% بين الرجال و 4% بين النساء.
من الأمور الهامة التي يجب أخذها في الاعتبار هو الدور الذي يلعبه العرق في انتشار المرض. فالنقرس يظهر بشكل أكثر شيوعاً بين شعوب الشامورو والماوري وقبائل بيما. ويعتقد الباحثون أن العوامل الغذائية السائدة في كل عرق قد تكون مسؤولة عن هذا الاختلاف في معدلات الانتشار.
تشير الأرقام والإحصائيات إلى أن الرجال أكثر عرضة للإصابة بالنقرس من النساء. ويعزى ذلك إلى أن هرمون الإستروجين، الذي يكون سائداً في النساء قبل سن اليأس، يساهم في تقليل مستويات حمض اليوريك في الدم. وتظهر الدراسات أن ذروة الإصابة بالمرض تحدث عادة بين سن 30 و 60 عاماً. وكقاعدة عامة، يرتفع مستوى حمض اليوريك في الدم لمدة تصل إلى 20 عاماً قبل ظهور أعراض النقرس. ففي الذكور، يبدأ ارتفاع حمض اليوريك عند البلوغ وتكون ذروة المرض بين العقدين الرابع والسادس من العمر. أما بالنسبة للإناث، فيبدأ ارتفاع حمض اليوريك عند سن اليأس وتكون ذروة المرض بين العقدين السادس والثامن من العمر.
يزداد احتمال الإصابة بالنقرس مع التقدم في العمر، حيث يصيب حوالي 1.3% من كبار السن (أكثر من 55 عاماً). ويعزى ذلك إلى عدة عوامل، منها ارتفاع معدلات الإصابة بمتلازمة الأيض، وأمراض الضغط والقلب، وما يترتب عليها من تناول أدوية تزيد من حمض اليوريك مثل مدرات البول والأسبرين.
ارشادات غذائية لمرضى النقرس
ماذا يجب أن يأكل مريض النقرس؟ هذا السؤال يطرحه الكثيرون. من الضروري لمرضى النقرس اتباع نظام غذائي صحي ومتوازن يساعد على التحكم في مستويات حمض اليوريك في الدم. التركيز يجب أن يكون على الأطعمة التي تقلل من إنتاج حمض اليوريك وتساعد على التخلص منه من الجسم.
الأطعمة الموصى بها:
- الفواكه والخضروات: تعتبر مصادر ممتازة للفيتامينات والمعادن ومضادات الأكسدة، كما أنها قليلة البيورينات.
- الحبوب الكاملة: مثل الأرز البني والشوفان، فهي غنية بالألياف وتساعد على تنظيم مستويات السكر في الدم.
- منتجات الألبان قليلة الدسم: مثل الحليب والزبادي، فهي مصادر جيدة للكالسيوم والبروتين.
- الماء: شرب كميات كافية من الماء يساعد على تخفيف حمض اليوريك في الدم وتسهيل إخراجه من الجسم.
الأطعمة التي يجب تجنبها أو تناولها بكميات قليلة:
- اللحوم الحمراء: مثل لحم البقر والضأن، فهي غنية بالبيورينات التي تزيد من إنتاج حمض اليوريك.
- المأكولات البحرية: مثل السردين والمحار، فهي أيضاً غنية بالبيورينات.
- المشروبات الكحولية: وخاصة البيرة، حيث أنها تزيد من إنتاج حمض اليوريك وتقلل من قدرة الجسم على التخلص منه.
- المشروبات المحلاة بالسكر: مثل العصائر والمشروبات الغازية، حيث أنها تزيد من خطر الإصابة بالنقرس.
- الأطعمة الغنية بالدهون المشبعة: حيث أنها تزيد من الالتهابات وتؤثر على مستويات حمض اليوريك.
من المهم جداً استشارة الطبيب أو أخصائي التغذية لوضع خطة غذائية مناسبة تأخذ في الاعتبار الحالة الصحية الفردية والأدوية التي يتناولها المريض.
المصادر والمراجع
- Judith Sondheimer , 2008 , current essential pediatrics , USA , McGraw Hill lange .
- Richard E. and others ,2004 , Nelson textbook of pediatrics ,USA , Saunders.
- Bradley marino and Katie Fine , 2009 , Blueprints pediatrics , USA , Lippincott Williams and Wilkins .